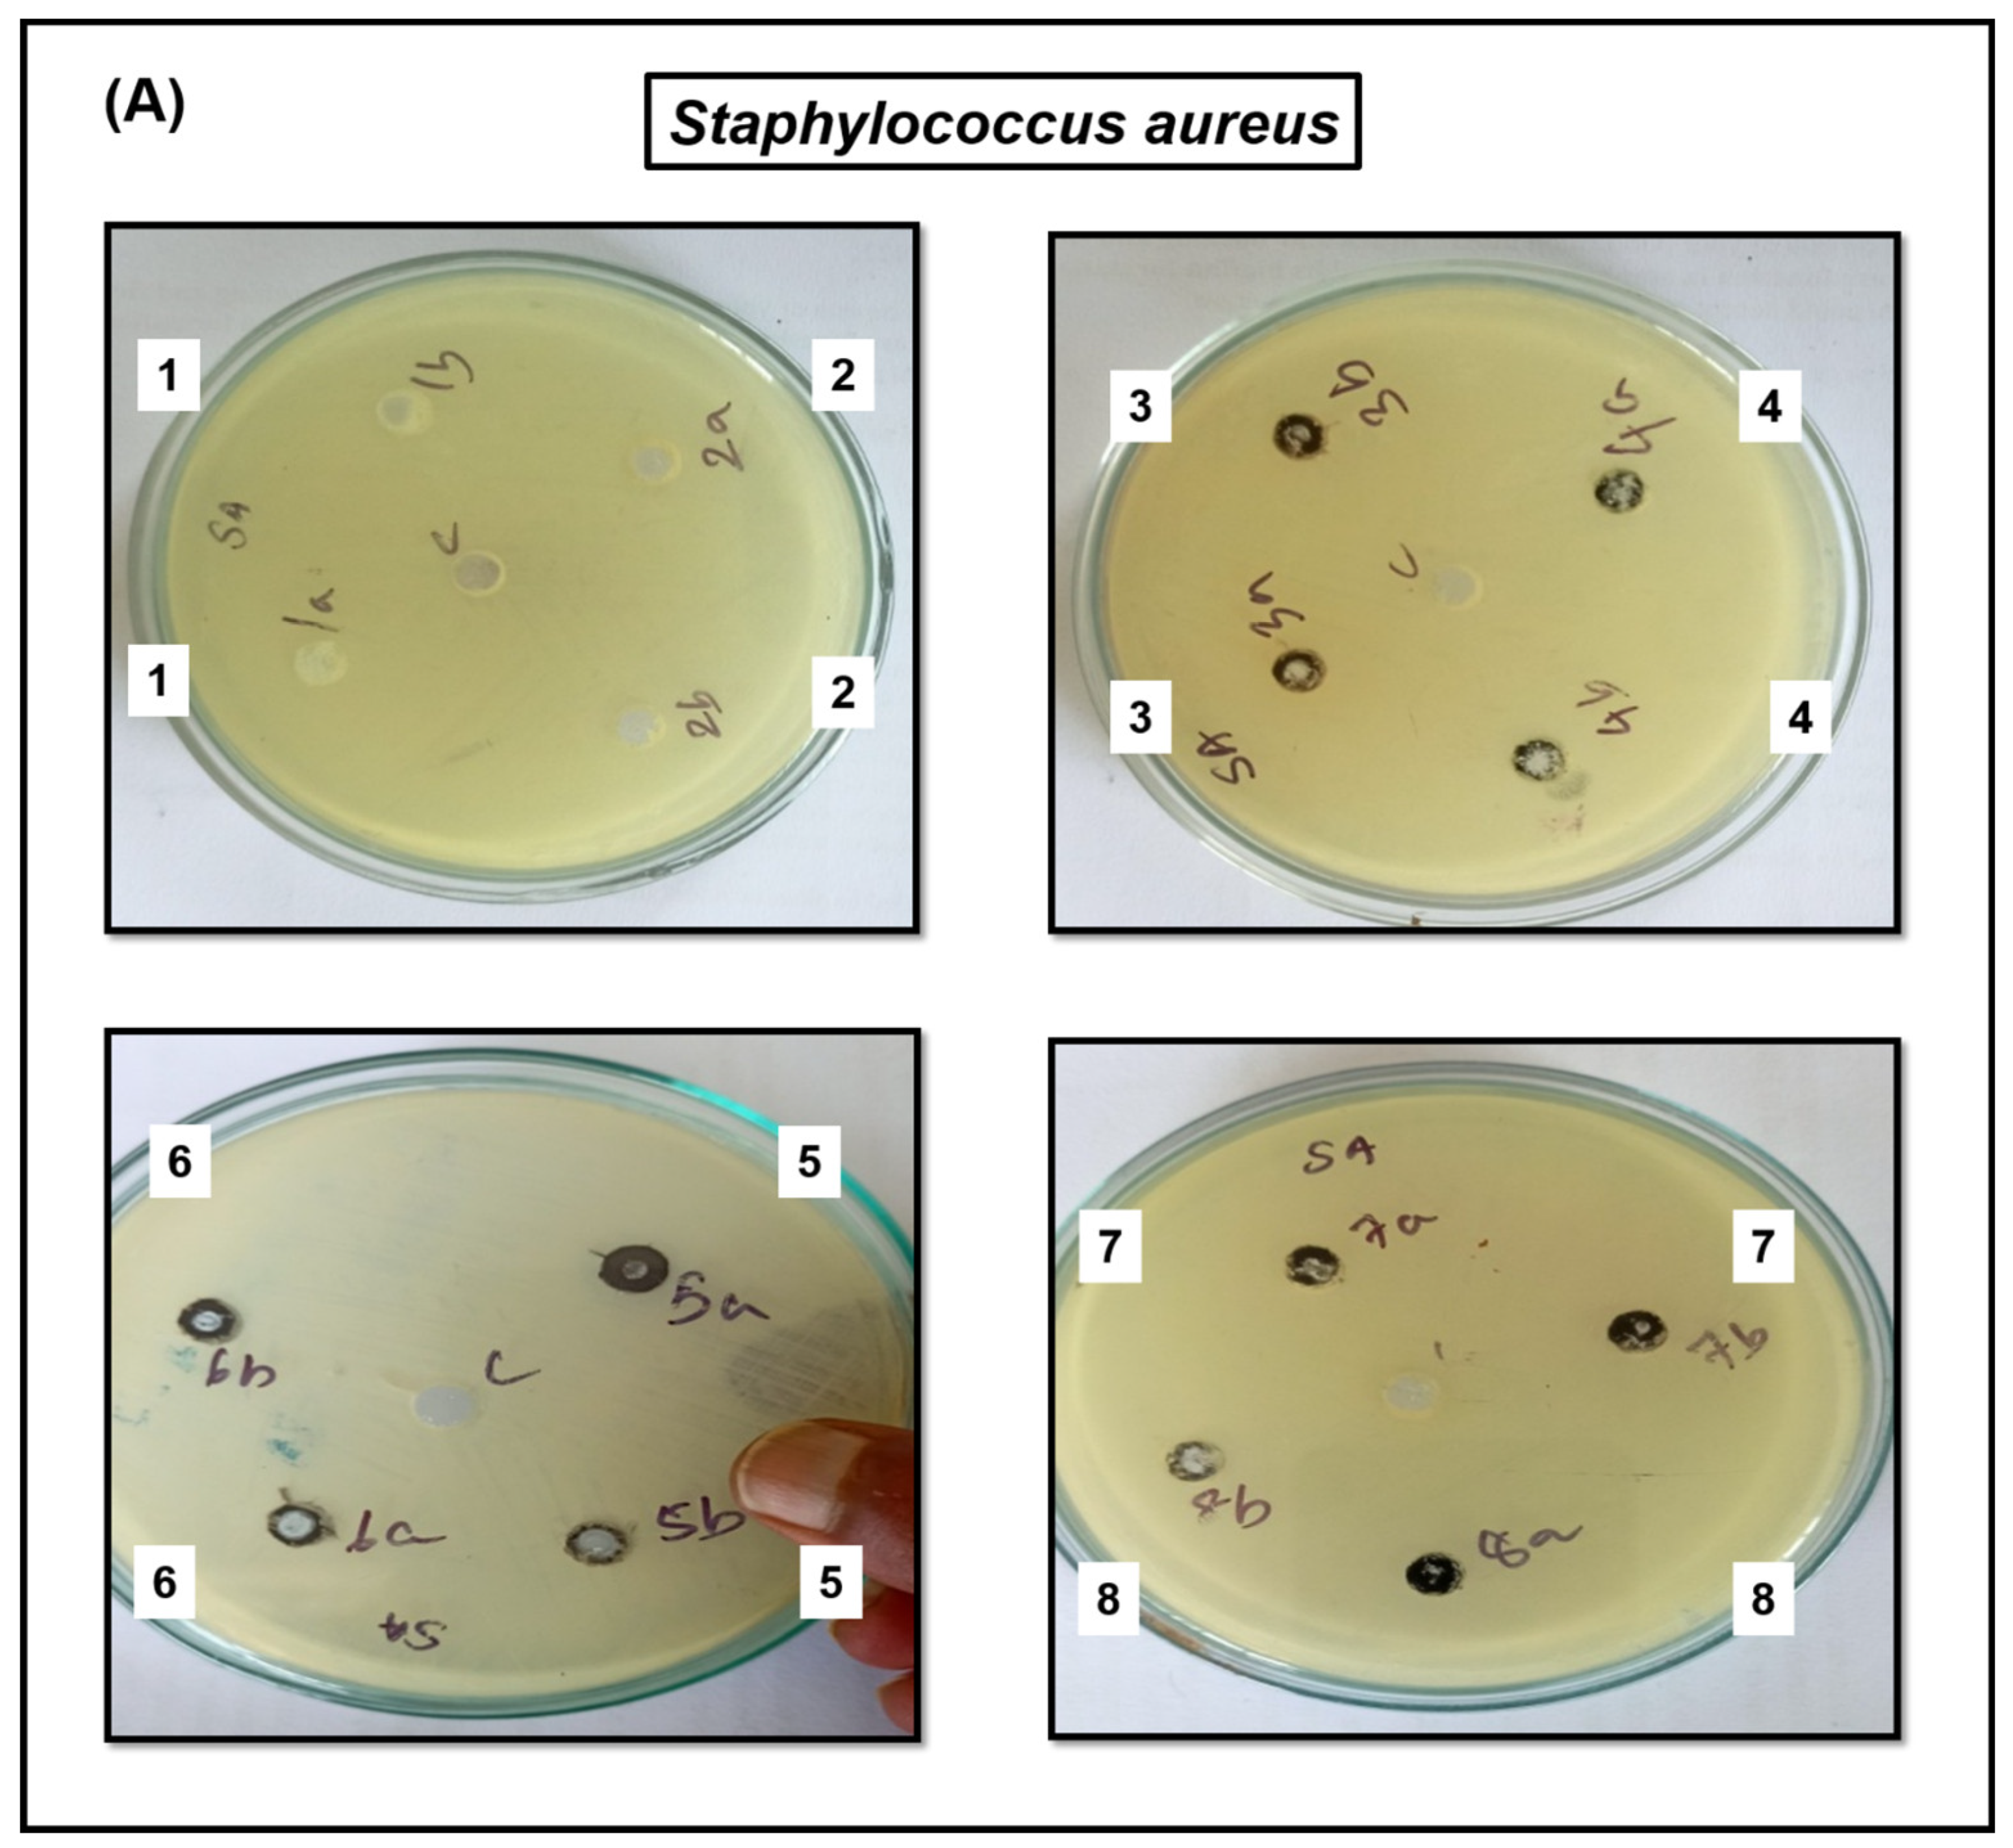
Jof 09 00310 g006a Jof 09 00310 g006a
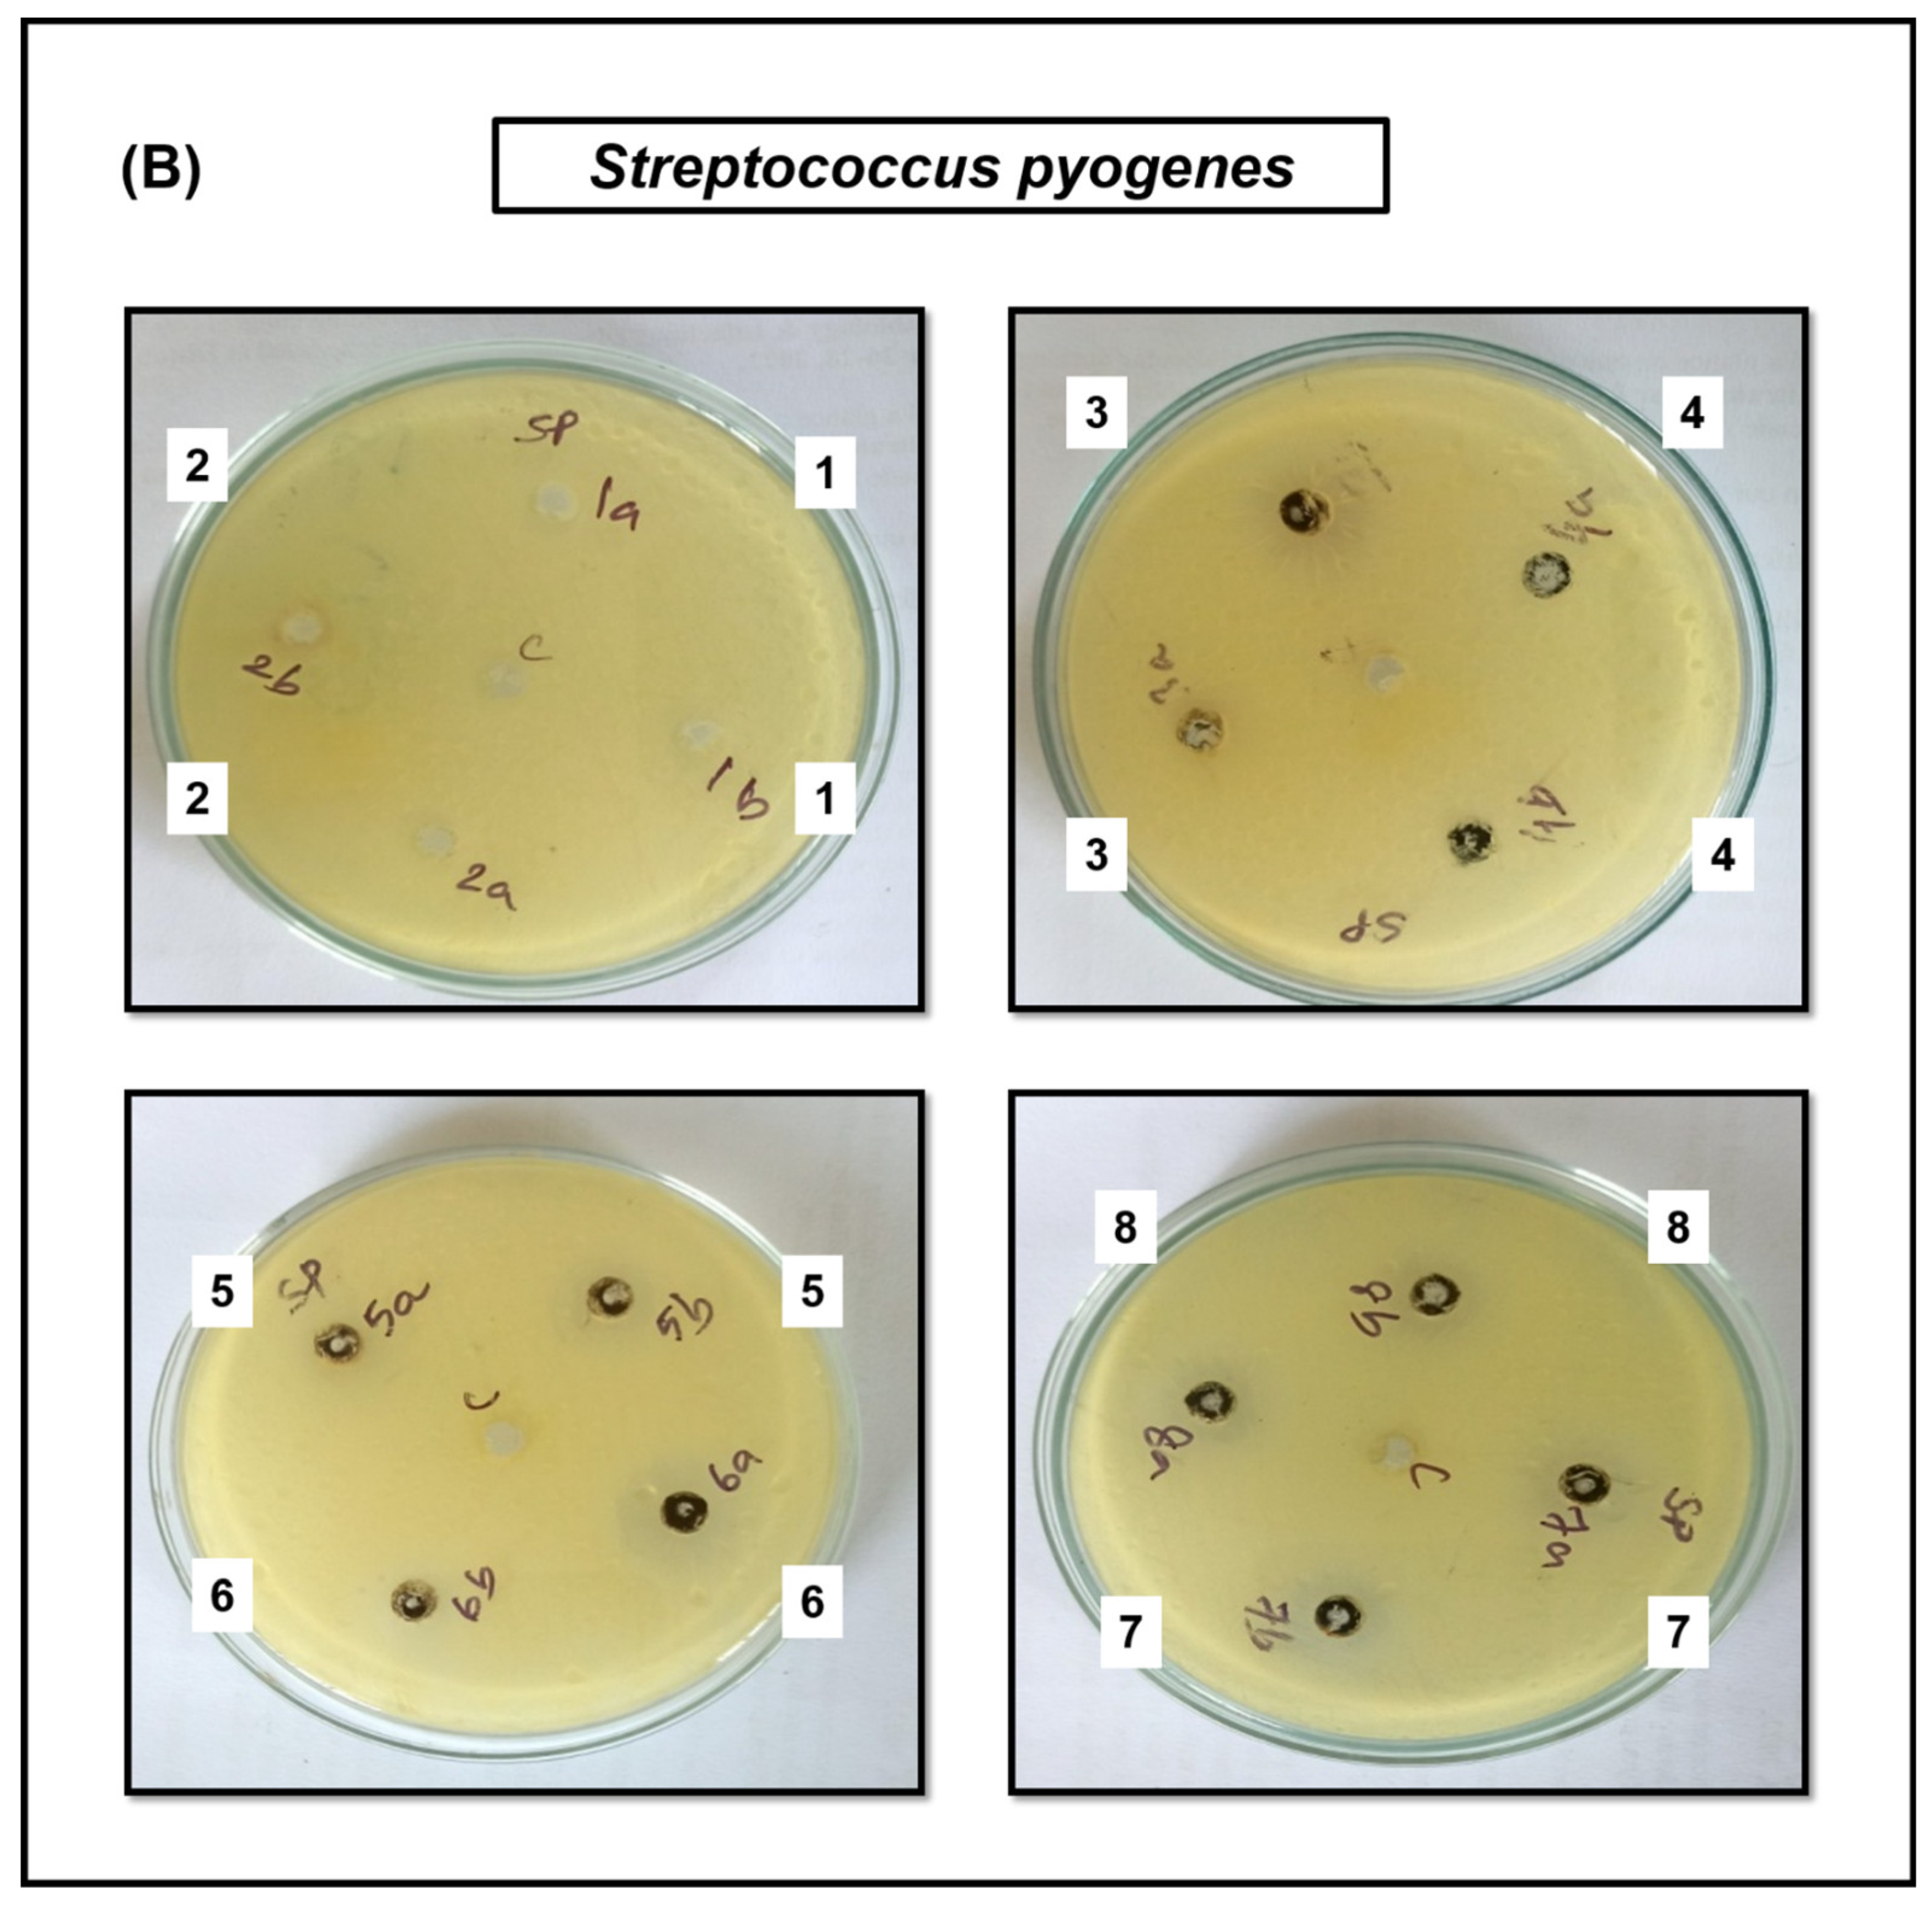
Jof 09 00310 g006b Jof 09 00310 g006b

Facile Synthesis and Characterization of Cupric Oxide Loaded 2D Structure Graphitic Carbon Nitride (g-C3N4) Nanocomposite: In Vitro Anti-Bacterial and Fungal Interaction Studies
Abstract
1. Introduction
2. Materials and Methods
2.1. Materials
2.2. Synthesis of g-C3N4
2.3. Synthesis of Cupric Oxide Loaded g-C3N4 Nanocomposites
2.4. Characterization Techniques
2.5. Anti-Bacterial Activity
2.5.1. Preparation of Inoculum
2.5.2. Agar Well Diffusion Method
2.6. Fungal Activity
Agar Well Diffusion Method
3. Results
3.1. X-ray Diffraction Method (XRD)
3.2. Scanning Electron Microscopy (SEM)
3.3. UV-Visible Diffuse Reflectance Spectroscopy (UV-Vis DRS)
3.4. Antimicrobial Activity
4. Discussion
5. Conclusions
Author Contributions
Funding
Institutional Review Board Statement
Informed Consent Statement
Data Availability Statement
Acknowledgments
Conflicts of Interest
References
- Shinde, R.S.; More, R.A.; Adole, V.A.; Koli, P.B.; Pawar, T.B.; Jagdale, B.S.; Desale, B.S.; Sarnikar, Y.P. Design, fabrication, antitubercular, antibacterial, antifungal and antioxidant study of silver doped ZnO and CuO nano candidates: A comparative pharmacological study. Curr. Opin. Green Sustain. Chem. 2021, 4, 100138. [Google Scholar] [CrossRef]
- Peng, Y.; Li, S.J.; Yan, J.; Tang, Y.; Cheng, J.P.; Gao, A.J.; Yao, X.; Ruan, J.J.; Xu, B.L. Research progress on phytopathogenic fungi and their role as biocontrol agents. Front. Microbiol. 2021, 12, 670135. [Google Scholar] [CrossRef]
- Gomes, E.V.; Costa, M.d.N.; de Paula, R.G.; Ricci de Azevedo, R.; da Silva, F.L.; Noronha, E.F.; José Ulhoa, C.; Neves Monteiro, V.; Elena Cardoza, R.; Gutiérrez, S. The Cerato-Platanin protein Epl-1 from Trichoderma harzianum is involved in mycoparasitism, plant resistance induction and self cell wall protection. Sci. Rep. 2015, 5, 17998. [Google Scholar] [CrossRef]
- Verma, A.; Anand, P.; Kumar, S.; Fu, Y.-P. Cu-cuprous/cupric oxide nanoparticles towards dual application for nitrophenol conversion and electrochemical hydrogen evolution. Appl. Surf. Sci. 2022, 578, 151795. [Google Scholar] [CrossRef]
- Giridasappa, A.; Rangappa, D.; Shanubhoganahalli Maheswarappa, G.; Marilingaiah, N.R.; Kagepura Thammaiah, C.; Shareef, I.M.; Kanchugarakoppal Subbegowda, R.; Doddakunche Shivaramu, P. Phytofabrication of cupric oxide nanoparticles using Simarouba glauca and Celastrus paniculatus extracts and their enhanced apoptotic inducing and anticancer effects. Appl. Nanosci. 2021, 11, 1393–1409. [Google Scholar] [CrossRef]
- Jithul, K.; Samra, K.S. Cupric Oxide based Supercapacitors: A Review. In Proceedings of the Journal of Physics: Conference Series, Wuhan, China, 18 September 2022; p. 012120. [Google Scholar]
- Sumathi, S.; Nehru, M.; Vidya, R. Synthesis, characterization and effect of precipitating agent on the antibacterial properties of cobalt ferrite nanoparticles. Trans. Indian Ceram. Soc. 2015, 74, 79–82. [Google Scholar] [CrossRef]
- Cuong, H.N.; Pansambal, S.; Ghotekar, S.; Oza, R.; Hai, N.T.T.; Viet, N.M.; Nguyen, V.-H. New frontiers in the plant extract mediated biosynthesis of copper oxide (CuO) nanoparticles and their potential applications: A review. Environ. Res. 2022, 203, 111858. [Google Scholar] [CrossRef]
- Rangarajan, S.; Verekar, S.; Deshmukh, S.K.; Bellare, J.R.; Balakrishnan, A.; Sharma, S.; Vidya, R.; Chimote, G. Evaluation of anti-bacterial activity of silver nanoparticles synthesised by coprophilous fungus PM0651419. IET Nanobiotechnol. 2018, 12, 106–115. [Google Scholar] [CrossRef]
- Hafeez, H.Y.; Lakhera, S.K.; Bellamkonda, S.; Rao, G.R.; Shankar, M.; Bahnemann, D.; Neppolian, B. Construction of ternary hybrid layered reduced graphene oxide supported g-C3N4-TiO2 nanocomposite and its photocatalytic hydrogen production activity. Int. J. Hydrog. Energy 2018, 43, 3892–3904. [Google Scholar] [CrossRef]
- Moradi, M.; Hasanvandian, F.; Isari, A.A.; Hayati, F.; Kakavandi, B.; Setayesh, S.R. CuO and ZnO co-anchored on g-C3N4 nanosheets as an affordable double Z-scheme nanocomposite for photocatalytic decontamination of amoxicillin. Appl. Catal. 2021, 285, 119838. [Google Scholar] [CrossRef]
- Thiyagarajan, K.; Samuel, S.; Kumar, P.S.; Babu, S.G.J.B.o.M.S. C3N4 supported on chitosan for simple and easy recovery of visible light active efficient photocatalysts. Bull. Mater. Sci. 2020, 43, 1–7. [Google Scholar] [CrossRef]
- Liu, Q.; Wang, X.; Yang, Q.; Zhang, Z.; Fang, X. Mesoporous g-C3N4 nanosheets prepared by calcining a novel supramolecular precursor for high-efficiency photocatalytic hydrogen evolution. Appl. Surf. Sci. 2018, 450, 46–56. [Google Scholar] [CrossRef]
- Bhuvaneswari, C.; Babu, S.G. Nanoarchitecture and surface engineering strategy for the construction of 3D hierarchical CuS-rGO/g-C3N4 nanostructure: An ultrasensitive and highly selective electrochemical sensor for the detection of furazolidone drug. J. Electroanal. Chem. 2022, 907, 116080. [Google Scholar] [CrossRef]
- Liu, Y.; Shen, S.; Li, Z.; Ma, D.; Xu, G.; Fang, B. Mesoporous g-C3N4 nanosheets with improved photocatalytic performance for hydrogen evolution. Mater. Charact. 2021, 174, 111031. [Google Scholar] [CrossRef]
- Wen, J.; Xie, J.; Chen, X.; Li, X. A review on g-C3N4-based photocatalysts. Appl. Surf. Sci. 2017, 391, 72–123. [Google Scholar] [CrossRef]
- Li, R.; Ren, Y.; Zhao, P.; Wang, J.; Liu, J.; Zhang, Y. Graphitic carbon nitride (g-C3N4) nanosheets functionalized composite membrane with self-cleaning and antibacterial performance. J. Hazard. Mater. 2019, 365, 606–614. [Google Scholar] [CrossRef] [PubMed]
- Sher, M.; Shahid, S.; Javed, M. Synthesis of a novel ternary (g-C3N4 nanosheets loaded with Mo doped ZnO nanoparticles) nanocomposite for superior photocatalytic and antibacterial applications. J. Photochem. Photobiol. B Biol. 2021, 219, 112202. [Google Scholar] [CrossRef]
- Gonelimali, F.D.; Lin, J.; Miao, W.; Xuan, J.; Charles, F.; Chen, M.; Hatab, S.R. Antimicrobial properties and mechanism of action of some plant extracts against food pathogens and spoilage microorganisms. Front. Microbiol. 2018, 9, 1639. [Google Scholar] [CrossRef] [PubMed]
- Induja, M.; Sivaprakash, K.; Karthikeyan, S.J.M.R.B. Facile green synthesis and antimicrobial performance of Cu2O nanospheres decorated g-C3N4 nanocomposite. Mater. Res. Bull. 2019, 112, 331–335. [Google Scholar] [CrossRef]
- Kublik, N.; Gomes, L.E.; Plaça, L.F.; Lima, T.H.; Abelha, T.F.; Ferencz, J.A.; Caires, A.R.; Wender, H.J.P. Metal-free g-C3N4/nanodiamond heterostructures for enhanced photocatalytic pollutant removal and bacteria photoinactivation. Photochem. 2021, 1, 302–318. [Google Scholar] [CrossRef]
- Bai, B.; Saranya, S.; Dheepaasri, V.; Muniasamy, S.; Alharbi, N.S.; Selvaraj, B.; Undal, V.S.; Gnanamangai, B.M. Biosynthesized copper oxide nanoparticles (CuO NPs) enhances the anti-biofilm efficacy against K. pneumoniae and S. aureus. J. King Saud Univ.-Sci. 2022, 34, 102120. [Google Scholar] [CrossRef]
- Selvaraj, S.P. Enhanced surface morphology of copper oxide (CuO) nanoparticles and its antibacterial activities. Mater. Today Proc. 2022, 50, 2865–2868. [Google Scholar] [CrossRef]
- Du, B.D.; Phu, D.V.; Quoc, L.A.; Hien, N.Q. Synthesis and investigation of antimicrobial activity of Cu2O nanoparticles/zeolite. J. Nanoparticles Res. 2017, 2017, 705684. [Google Scholar] [CrossRef]
- Salem, S.S.; Ali, O.M.; Reyad, A.M.; Abd-Elsalam, K.A.; Hashem, A.H. Pseudomonas indica-mediated silver nanoparticles: Antifungal and antioxidant biogenic tool for suppressing mucormycosis fungi. J. Fungus. 2022, 8, 126. [Google Scholar] [CrossRef]
- Liu, Y.; Huang, X.; Yu, Z.; Yao, L.; Guo, S.; Zhao, W.J.C. Environmentally Friendly Non-Metal Solar Photocatalyst C3N4 for Efficient Nitrogen Fixation as Foliar Fertilizer. ChemistrySelect 2020, 5, 7720–7727. [Google Scholar] [CrossRef]
- Kalia, A.; Abd-Elsalam, K.A.; Kuca, K. Zinc-based nanomaterials for diagnosis and management of plant diseases: Ecological safety and future prospects. J. Fungus 2020, 6, 222. [Google Scholar] [CrossRef] [PubMed]
- Chen, J.; Mao, S.; Xu, Z.; Ding, W. Various antibacterial mechanisms of biosynthesized copper oxide nanoparticles against soilborne Ralstonia solanacearum. RSC Adv. 2019, 9, 3788–3799. [Google Scholar] [CrossRef]
- Soni, A.; Kaushal, D.; Kumar, M.; Sharma, A.; Maurya, I.K.; Kumar, S. Synthesis, characterizations and antifungal activities of copper oxide and differentially doped copper oxide nanostructures. Mater. Today Proc. 2022, in press. [Google Scholar] [CrossRef]
- Kumar, P.; Inwati, G.K.; Mathpal, M.C.; Ghosh, S.; Roos, W.; Swart, H.C. Defects induced enhancement of antifungal activities of Zn doped CuO nanostructures. Appl. Surf. Sci. 2021, 560, 150026. [Google Scholar] [CrossRef]
- Zaki, S.A.; Ouf, S.A.; Albarakaty, F.M.; Habeb, M.M.; Aly, A.A.; Abd-Elsalam, K.A. Trichoderma harzianum-mediated ZnO nanoparticles: A green tool for controlling soil-borne pathogens in cotton. J. Fungus 2021, 7, 952. [Google Scholar] [CrossRef] [PubMed]
- Alghuthaymi, M.A.; Abd-Elsalam, K.A.; AboDalam, H.M.; Ahmed, F.K.; Ravichandran, M.; Kalia, A.; Rai, M.J. Trichoderma: An eco-friendly source of nanomaterials for sustainable agroecosystems. J. Fungus 2022, 8, 367. [Google Scholar] [CrossRef] [PubMed]

| Samples | S. aureus (mm) | S. pyogenes (mm) | E. coli (mm) | P. aeruginosa (mm) |
|---|---|---|---|---|
| Bulk-g-C3N4 | R | R | R | R |
| Exfoliated g-C3N4 | R | R | R | R |
| CuO | 8 | 12 | 6 | 8 |
| 30 wt% CuO/g-C3N4 | R | R | R | R |
| 40 wt% CuO/g-C3N4 | 16 | 16 | 10 | 12 |
| 50 wt% CuO/g-C3N4 | 16 | 16 | 10 | 14 |
| 60 wt% CuO/g-C3N4 | 18 | 18 | 12 | 14 |
| 70 wt% CuO/g-C3N4 | 18 | 18 | 12 | 14 |
Disclaimer/Publisher’s Note: The statements, opinions and data contained in all publications are solely those of the individual author(s) and contributor(s) and not of MDPI and/or the editor(s). MDPI and/or the editor(s) disclaim responsibility for any injury to people or property resulting from any ideas, methods, instructions or products referred to in the content. |
© 2023 by the authors. Licensee MDPI, Basel, Switzerland. This article is an open access article distributed under the terms and conditions of the Creative Commons Attribution (CC BY) license (https://creativecommons.org/licenses/by/4.0/).
Share and Cite
Priya, R.L.; Kariyanna, B.; Karthi, S.; Sudhakaran, R.; Babu, S.G.; Vidya, R. Facile Synthesis and Characterization of Cupric Oxide Loaded 2D Structure Graphitic Carbon Nitride (g-C3N4) Nanocomposite: In Vitro Anti-Bacterial and Fungal Interaction Studies. J. Fungi 2023, 9, 310. https://doi.org/10.3390/jof9030310
Priya RL, Kariyanna B, Karthi S, Sudhakaran R, Babu SG, Vidya R. Facile Synthesis and Characterization of Cupric Oxide Loaded 2D Structure Graphitic Carbon Nitride (g-C3N4) Nanocomposite: In Vitro Anti-Bacterial and Fungal Interaction Studies. Journal of Fungi. 2023; 9(3):310. https://doi.org/10.3390/jof9030310
Chicago/Turabian StylePriya, Rajendran Lakshmi, Bheeranna Kariyanna, Sengodan Karthi, Raja Sudhakaran, Sundaram Ganesh Babu, and Radhakrishnan Vidya. 2023. "Facile Synthesis and Characterization of Cupric Oxide Loaded 2D Structure Graphitic Carbon Nitride (g-C3N4) Nanocomposite: In Vitro Anti-Bacterial and Fungal Interaction Studies" Journal of Fungi 9, no. 3: 310. https://doi.org/10.3390/jof9030310
APA StylePriya, R. L., Kariyanna, B., Karthi, S., Sudhakaran, R., Babu, S. G., & Vidya, R. (2023). Facile Synthesis and Characterization of Cupric Oxide Loaded 2D Structure Graphitic Carbon Nitride (g-C3N4) Nanocomposite: In Vitro Anti-Bacterial and Fungal Interaction Studies. Journal of Fungi, 9(3), 310. https://doi.org/10.3390/jof9030310

